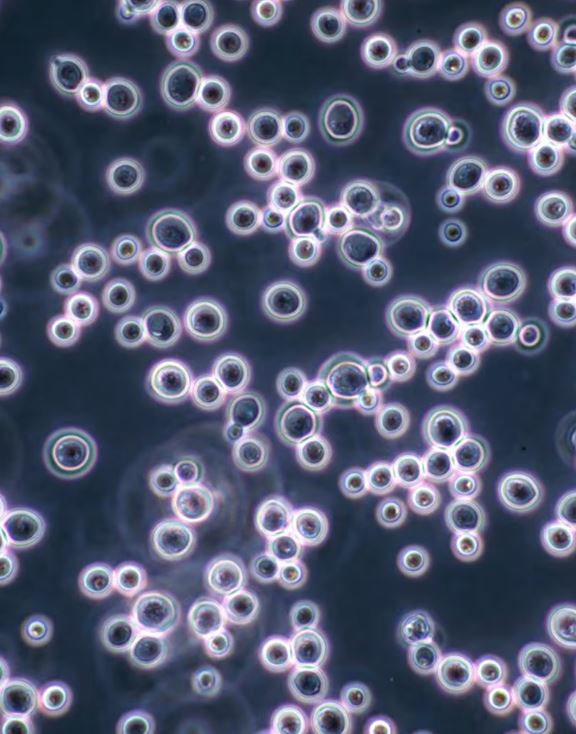

Automatické zariadenie na rehydratáciu a aklimatizáciu kvasiniek

Reactivateur 60 je určený na automatickú prípravu kvasiniek pred inokuláciou. Zariadenie zabezpečuje riadenú rehydratáciu a aklimatizáciu kvasiniek, čím prispieva k stabilnému a reprodukovateľnému priebehu alkoholového kvasenia.
DOMINANCIA KVASINIEK
Optimalizácia kvasenia muštov, refermentácie vína a jablčno-mliečnej fermentácie (MLF) závisí predovšetkým od dosiahnutia dominancie vybraných mikroorganizmov. Výber kmeňov s požadovanými technologickými vlastnosťami je účinný iba v prípade, že tieto kmene prevezmú prevahu nad pôvodnou mikroflórou.
Na zabezpečenie dominancie je potrebné inokulovať kvasinky v koncentrácii minimálne 20-násobne vyššej, než je koncentrácia prirodzene prítomných kvasiniek.
Za účelom štandardizácie prípravy inokulačných kvasiniek a minimalizácie vplyvu ľudského faktora bol vyvinutý modelový rad Reactivateur 60. Jeho konštrukcia bola postupne optimalizovaná s dôrazom na technologické požiadavky vinárskej praxe.
VÝHODY:
- Skrátenie lag fázy kvasiniek (rýchlejší nástup kvasenia)
- Pravidelný a stabilný priebeh alkoholového kvasenia
- Zabezpečenie prevahy (dominancie) inokulovaných kvasiniek počas fermentácie
- Zlepšenie kinetiky kvasenia aj v náročných podmienkach
- Záruka správnej rehydratácie a aklimatizácie kvasiniek
- Možnosť reaktivácie pri zastavenom kvasení
- Príprava pied de cuve (štartovacia kultúra) pre druhotné kvasenie v tanku alebo vo fľaši
PREVÁDZKA:
Na reaktiváciu (rehydratáciu a aklimatizáciu) kvasiniek sú potrebné iba dva jednoduché kroky:
- Nastavte množstvo kvasiniek určených na rehydratáciu a stlačte tlačidlo ŠTART. Zariadenie automaticky napustí predvolený objem vody zodpovedajúci zvolenému typu kvasiniek a následne ju ohreje na nastavenú teplotu 38 °C.
- Zvukový signál upozorní obsluhu, že je možné pridať kvasinky a začať fázu rehydratácie. Zmes vody a kvasiniek následne prechádza striedajúcimi sa fázami miešania, prestávky a aerácie. Systém potom postupne (kontrolovane) pridáva mušt do pripravených kvasiniek. Dávkovanie muštu môže prebiehať dvoma spôsobmi: podľa času alebo podľa teplotného rozdielu – podľa toho, ktorá podmienka sa dosiahne skôr.
| MODEL | MNOŽSTVO KVASINIEK (kg) |
|---|---|
| 60/300 | Max. 6 |
| 60/1000 | Max. 20 |
| 60/1500 | Max. 30 |
| 60/2000 | Max. 40 |
| 60/3000 | Max.50 |
| 60/ECO | Min. 0,5 |

Dotyková obrazovka

Jednotka s dvojčinným pneumatickým ventilom, pohonom (aktuátorom), elektromagnetickým ventilom a čerpadlom

Prietokomer vody

Enowater

Sprchová rozprašovacia tryska (sprinklerová tryska)
